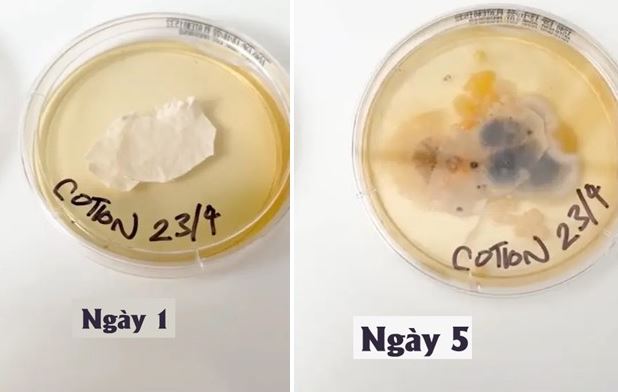
Món đồ trên giường bẩn hơn bồn cầu gấp 17.000 lần, có thể gây viêm màng não, viêm phổi nếu không làm 1 việc

Tìm kiếm: mái-tóc-dài
Những hình ảnh về đám cưới của nam thần người Myanmer - Paing Takhon đang thực sự gây xôn xao mạng xã hội.
Trái với gương mặt ngọt ngào, vóc dáng của Điền Hi Vi khiến ai cũng ngỡ ngàng.
Danh tính người phụ nữ Việt đầu tiên trở thành hoàng hậu ở nước ngoài: Sau 1 năm chọn xuất giá đi tu
Đây là cuộc hôn nhân do sự sắp đặt của Thượng hoàng Trần Nhân Tông nhằm mục đích mở rộng bờ cõi nước Đại Việt.
Theo một báo cáo nghiên cứu, một chiếc vỏ gối chưa giặt có thể chứa 3 triệu vi khuẩn chỉ sau một tuần, cao gấp khoảng 17.000 lần so với một chiếc bồn cầu.
Trái với gương mặt ngọt ngào, vóc dáng của Điền Hi Vi khiến ai cũng ngỡ ngàng.
Dù đã nín nhịn hết sức để buổi ra mắt được thành công nhưng cuối cùng Thu vẫn phải lên tiếng đáp trả những pha bắt bẻ quá quắt của mẹ bạn trai.
Tôi vừa ngồi lên xe cạnh ghế lái thì cô ấy cáu kỉnh, sao lại có một cô gái dị như thế trên đời cơ chứ!
Vương Ngữ Yên dù được miêu tả là có nhan sắc thiên tiên xuất thần nhưng nàng vẫn không phải là người đẹp nhất trong các tiểu thuyết kiếm hiệp của Kim Dung. Vì sao?
Có lẽ nhờ cuộc sống hạnh phúc, đầm ấm, nên ở tuổi ngoài thất thập, NSND Thanh Loan vẫn toát lên vẻ đẹp thanh lịch, dịu dàng.
Ban đầu mối quan hệ của cả hai vấp phải sự phản đối của nhà gái, nhưng sau đó họ vẫn đến được bên nhau.
Nữ sinh phim Hàn này có diện mạo nổi bật nhưng tính tình thì không ai mê nổi.
Ai Cập cổ đại, một nền văn minh cổ xưa và huyền bí. Nó nổi tiếng với những kim tự tháp đồ sộ, những ngôi đền hùng vĩ và những tác phẩm điêu khắc tinh xảo, nhưng đằng sau nền văn minh cổ đại này lại ẩn chứa vô số bí ẩn hấp dẫn.
Dàn mỹ nhân của phim Hoa ngữ này gây sốt bởi vẻ đẹp nóng bỏng.
Các nhà khảo cổ cho rằng xác ướp này còn được chôn với các đồ vật đặc biệt.
DNVN - Dù chịu ảnh hưởng không ít sau những lùm xùm của hoa hậu Ý Nhi hậu đăng quang Miss World Vietnam 2023 và hạn chế xuất hiện, á hậu Minh Kiên vẫn nhận được nhiều lời khen từ khán giả bởi vẻ đẹp tự nhiên cùng nhan sắc ngày càng thăng hạng.
End of content
Không có tin nào tiếp theo